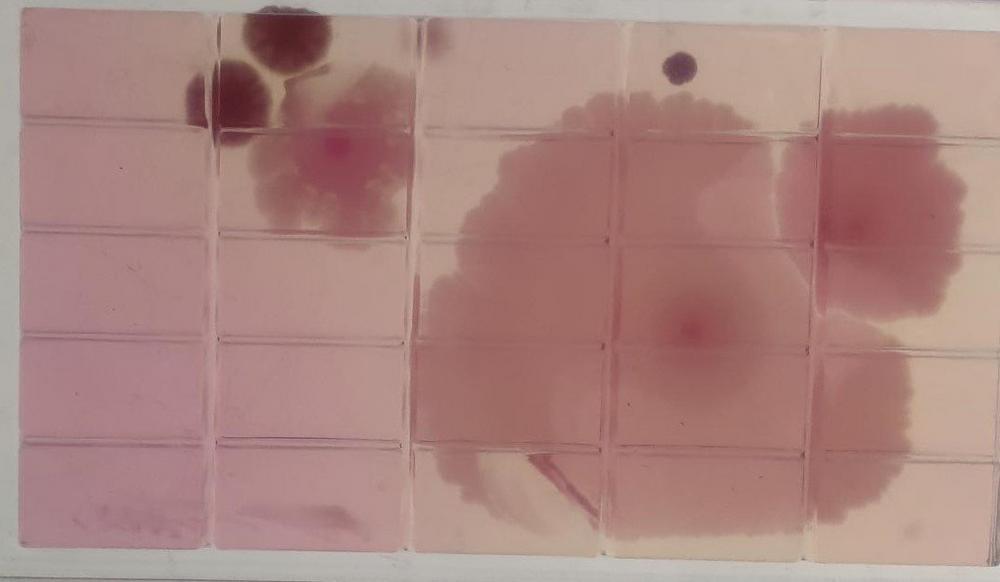

Newly developed mini data loggers allow glass producers and filling companies to carry out line inspections in the original container in direct contact with the filling material. This allows unrestricted passage through the entire production line. In filling plants for beverages, food or pharmaceutical products, damage to the container or even glass breakage can occur […]
continue reading